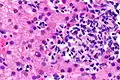

List of immune cells
This is a list of immune cells, also known as white blood cells, white cells, leukocytes, or leucocytes. They are cells involved in protecting the body against both infectious disease and foreign invaders.[1]
| Image | Name | Subtype | Class | Alternate names | Diameter (μm) | Main targets | References |
|---|---|---|---|---|---|---|---|
|
Neutrophil | Granulocyte | Neutrophil |
|
12-15 | [2][3][4] | |
|
Eosinophil | Granulocyte | Eosinophil |
|
12-15 |
|
[2][3] |
|
Basophil | Granulocyte | Basophil |
|
12-15 |
|
[2][3][5] |
|
Mast cell | Granulocyte | Mast cell |
|
8-20 |
|
[6][7] |
|
Macrophage | Monocyte | Macrophage | 20-21 |
|
[8][9] | |
|
Histiocyte | Monocyte | Macrophage |
|
20-21 |
|
[10][8] |
|
Kupffer cell | Monocyte | Macrophage |
|
20-21 |
|
[11][8] |
|
Alveolar macrophage | Monocyte | Macrophage |
|
20-21 |
|
[8] |
| Dendritic cell | Monocyte | Dendritic cell |
|
10-15 |
|
[12][13] | |
|
B cell | Lymphocyte | B cell |
|
8-10 |
|
[14][4] |
|
Plasma cell | Lymphocyte | B cell |
|
8-10 |
|
[4][15] |
|
Memory B cell | Lymphocyte | B cell |
|
8-10 |
|
[4][16] |
|
Killer T cell | Lymphocyte | T cell |
|
8-10 |
|
[4][17] |
|
Memory T cell | Lymphocyte | T cell |
|
8-10 |
|
[4][18] |
|
T helper cell | Lymphocyte | T cell |
|
8-10 |
|
[4][19] |
|
Natural killer T cell | Lymphocyte | T cell |
|
6-7 |
|
[20][21] |
|
Innate lymphoid cell | Lymphocyte | Innate lymphoid cell |
|
~6 |
|
[22][23] |
|
Natural killer cell | Lymphocyte | Innate lymphoid cell |
|
6-7 |
|
[21][24] |
References
- ^ "Leukocyte". National Cancer Institute. U.S. National Institutes of Health. 2011-02-02. Retrieved 2023-08-25.
- ^ a b c Wheater PR (1980). Functional histology. Internet Archive. Churchill Livingstone. ISBN 978-0-443-01657-8.
- ^ a b c Alberts B, Johnson A, Lewis J, Raff M, Roberts K, Walter P (2002). "Table 22-1, Blood Cells". Molecular Biology of the Cell (4th ed.). Garland Science. Retrieved 2023-08-27.
- ^ a b c d e f g Cano RL, Lopera HD (2013-07-18). "Introduction to T and B lymphocytes". In Anaya JM, Shoenfeld Y, Rojas-Villarraga A, Levy RA, Cervera R (eds.). Autoimmunity: From Bench to Bedside [Internet]. El Rosario University Press. Retrieved 2023-08-27.
- ^ "Basophil". Wiktionary, the free dictionary. 2023-08-11. Retrieved 2023-08-27.
- ^ Schulman ES, Kagey-Sobotka A, MacGlashan DW, Adkinson NF, Peters SP, Schleimer RP, Lichtenstein LM (October 1983). "Heterogeneity of human mast cells". Journal of Immunology. 131 (4): 1936–1941. doi:10.4049/jimmunol.131.4.1936. PMID 6194221. S2CID 30353975.
- ^ Krystel-Whittemore M, Dileepan KN, Wood JG (2016). "Mast Cell: A Multi-Functional Master Cell". Frontiers in Immunology. 6: 620. doi:10.3389/fimmu.2015.00620. PMC 4701915. PMID 26779180.
- ^ a b c d Krombach F, Münzing S, Allmeling AM, Gerlach JT, Behr J, Dörger M (September 1997). "Cell size of alveolar macrophages: an interspecies comparison". Environmental Health Perspectives. 105 (Suppl 5): 1261–1263. doi:10.2307/3433544. JSTOR 3433544. PMC 1470168. PMID 9400735.
- ^ Mahla RS, Kumar A, Tutill HJ, Krishnaji ST, Sathyamoorthy B, Noursadeghi M, et al. (January 2021). "NIX-mediated mitophagy regulate metabolic reprogramming in phagocytic cells during mycobacterial infection". Tuberculosis. 126: 102046. doi:10.1016/j.tube.2020.102046. PMID 33421909. S2CID 231437641.
- ^ Cline MJ (November 1994). "Histiocytes and histiocytosis". Blood. 84 (9): 2840–53. doi:10.1182/blood.V84.9.2840.2840. PMID 7524755.
- ^ Basit H, Tan ML, Webster DR (2023). "Histology, Kupffer Cell". StatPearls. Treasure Island (FL): StatPearls Publishing. PMID 29630278. Retrieved 2023-08-25.
- ^ "Cell diameter and total protein of mature den - Mammals - BNID 113239". bionumbers.hms.harvard.edu. Retrieved 2023-08-27.
- ^ Monga I, Kaur K, Dhanda SK (May 2022). "Revisiting hematopoiesis: applications of the bulk and single-cell transcriptomics dissecting transcriptional heterogeneity in hematopoietic stem cells". Briefings in Functional Genomics. 21 (3): 159–176. doi:10.1093/bfgp/elac002. PMID 35265979.
- ^ Alberts B, Johnson A, Lewis J, Raff M, Roberts K, Walter P (2002). "B Cells and Antibodies". Molecular Biology of the Cell (4th ed.). Garland Science. Retrieved 2023-08-27.
- ^ "Plasma cell | Description & Antibody Production | Britannica". www.britannica.com. Retrieved 2023-08-29.
- ^ Seifert M, Küppers R (December 2016). "Human memory B cells". Leukemia. 30 (12): 2283–2292. doi:10.1038/leu.2016.226. PMID 27499139. S2CID 28936531.
- ^ Alberts B, Johnson A, Lewis J, Raff M, Roberts K, Walter P (2002). "Helper T Cells and Lymphocyte Activation". Molecular Biology of the Cell (4th ed.). Garland Science. Retrieved 2023-08-27.
- ^ Rahimi RA, Luster AD (2018). Chemokines: Critical Regulators of Memory T Cell Development, Maintenance, and Function. Advances in Immunology. Vol. 138. pp. 71–98. doi:10.1016/bs.ai.2018.02.002. ISBN 9780128151884. PMC 6191293. PMID 29731007.
- ^ Burren OS, Rubio García A, Javierre BM, Rainbow DB, Cairns J, Cooper NJ, et al. (September 2017). "Chromosome contacts in activated T cells identify autoimmune disease candidate genes". Genome Biology. 18 (1): 165. doi:10.1186/s13059-017-1285-0. PMC 5584004. PMID 28870212.
- ^ Wu L, Van Kaer L (January 2011). "Natural killer T cells in health and disease". Frontiers in Bioscience. 3 (1): 236–251. doi:10.2741/S148. PMC 3626278. PMID 21196373.
- ^ a b Dickinson AJ, Meyer M, Pawlak EA, Gomez S, Jaspers I, Allbritton NL (April 2015). "Analysis of sphingosine kinase activity in single natural killer cells from peripheral blood". Integrative Biology. 7 (4): 392–401. doi:10.1039/c5ib00007f. PMC 4566154. PMID 25786072.
- ^ Spits H, Cupedo T (2012-04-23). "Innate lymphoid cells: emerging insights in development, lineage relationships, and function". Annual Review of Immunology. 30 (1): 647–675. doi:10.1146/annurev-immunol-020711-075053. PMID 22224763.
- ^ de Lucía Finkel P, Sherwood C, Saranchova I, Xia W, Munro L, Pfeifer CG, et al. (June 2021). "Serum free culture for the expansion and study of type 2 innate lymphoid cells". Scientific Reports. 11 (1): 12233. Bibcode:2021NatSR..1112233D. doi:10.1038/s41598-021-91500-z. PMC 8192527. PMID 34112824.
- ^ Vivier E, Raulet DH, Moretta A, Caligiuri MA, Zitvogel L, Lanier LL, et al. (January 2011). "Innate or adaptive immunity? The example of natural killer cells". Science. 331 (6013): 44–49. Bibcode:2011Sci...331...44V. doi:10.1126/science.1198687. PMC 3089969. PMID 21212348.
.png)
.png)
.png)

.jpg)

.png)



.jpg)
.jpg)
.jpg)
.jpg)